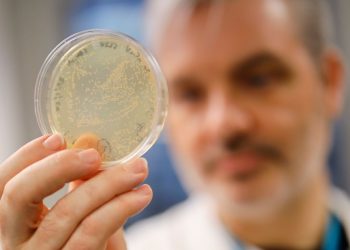
teacher being tested

Living in London
Things To Do Today In London: Wednesday 4 March 2020
New exhibition Among The Trees opens. Issues to do MADE IN ITALY: Cinema Made In Italy, an annual movie pageant...
Read moreDetailsPolice issue update after pedestrian left fighting for life
Police issue update after pedestrian left fighting for life in Hadleigh. More on this story HERE. Emergency companies rushed to...
Read moreDetailsMan airlifted to hospital with serious injuries
A person has been airlifted to hospital with severe accidents after a crash he was concerned in closed a serious...
Read moreDetailsInvestor launches London property fund with £100m fund
Alpamint Capital and DN Capital, the property investor and operator based by David Nourani, are collaborating to launch the latter’s...
Read moreDetailsWin 2 tickets to see Tori Kelly LIVE in London!
? COMPETITION TIME ? WE ARE GIVING AWAY 2 TICKETS TO SEE @torikelly AT THE @RoundhouseLDN ON MONDAY, MARCH 16TH!...
Read moreDetails‘Hidden’ path from Cornwall to London
The battle was over however his gruelling journey had simply begun. Lieutenant John Richards Lapenotière, captain of the small navy...
Read moreDetailsSchool forced to close and ‘unwell’ teacher being tested
Schoolchildren throughout town are being warned to remain house if they've returned from areas affected by coronavirus. Pupils at a...
Read moreDetailsAnthony Joshua next fight
As Tyson Fury and Deontay Wilder kind out the particulars for his or her necessary third struggle later this yr,...
Read moreDetailsJehnny Beth Announces Tiny London Solo Show | Live news
Savages could be shifting to the background however these are busy occasions for Jehnny Beth. The singer is gearing as...
Read moreDetailsLondon office sends staff home as Britons face quarantine
A Nottinghamshire Police officer has reportedly been taken off-duty and suggested to remain at house as a precaution following a...
Read moreDetails

-(2)-350x250.jpg)
